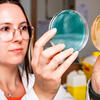
©Cyril Frésillon / GMGM / CNRS Images Petri dish hold by a woman, one green and one orange

You are here
Studying Bees with Connected Flowers
Your are conducting a study to better understand the behaviour of bees by collecting data in their natural environment via an automated system. This experiment, called ‘Abeilles-biodiversité’ (‘Bees and biodiversity’), involves students from the Lycée Julliot-de-la-Morandière in Granville, Normandy, with support from the Dassault Systèmes Foundation.1 How did this project come about?
Mathieu Lihoreau:2 When teachers at the Granville high school contacted me two years ago about a project by technology students to build connected hives, I sent them some tips. I then visited them to present my work on the behaviour of bees and, in particular, my ‘connected flower’ project. I gave the students specifications, i.e. a description of the final product and its application. With their teachers, they looked for technical solutions to develop a prototype. They designed the various modules, assembled them, and successfully tested the flower with real bees. Having tried a model together, we now need to improve it and find ways of making it replicable at low cost, for mass production and laboratory use.
What exactly are these connected flowers?
M. L.: They are primarily a research tool. Despite several thousand years of domestication and more than a century of modern scientific investigations into the behaviour and cognition of bees, little is known about how these insects select the flowers available in their environment and move among them. This ‘artificial’ specimen, which is placed among natural ones, attracts bees to a resource of defined quality, in a precise spot and for a given period of time. We came up with a system, vaguely resembling a flower, that delivers controlled quantities of artificial nectar and pollen, records the visits of the bees that come to forage, and identifies them individually. Eventually, these devices will be able to communicate with one another, creating true ‘connected fields.’
Foraging is a complex task. You mentioned a lack of fundamental understanding of this behaviour.
M. L.: This is due to the difficulty of tracking large numbers of individuals, sometimes several hundred bees in a single colony, over long distances and long periods of time. For instance, a honeybee can forage for about two weeks and make about 30 trips a day. On each trip, it may visit several tens or even hundreds of flowers spread out over distances of several kilometres. To understand this behaviour, we need improved monitoring of the environment and automated data collection. With connected flowers, we will be able to study how bees exploit resources as a function both of their spatial distribution and of the nutritional quality of their nectar and pollen. Improving our understanding of this basic behaviour will also enable us to elucidate pollination dynamics, which is essential for plant reproduction and ecosystem maintenance.
With bee populations declining in France and across the world, can this project also raise awareness of environmental issues among young—and not so young—people?
M. L.: Participatory science approaches are becoming increasingly common. These projects are of interest to us for a number of reasons. On the one hand, they make it possible to involve large numbers of people from outside the academic world, who often see things through fresh eyes. And on the other, they help the general public to become aware of our areas of research, which sometimes have a social dimension, as is the case for the decline of pollinating insects. The involvement of the students in the connected flower experiment went way beyond their teachers’ expectations: they even presented their project at the Olympiades des Métiers de Caen (Caen Career Fair) last April. A number of them have discovered the world of bees and the issues surrounding their decline, which are not necessarily dealt with in technical courses. We are increasingly using this participatory approach. Together with my colleagues, we have launched larger-scale projects such as EuroFrelon 2017, which seeks the help of amateurs to trap Asian hornets in their gardens or apiaries throughout Europe. The idea is to shed light on the very rapid invasion of this predator, which was first introduced into the South of France in 2004. I am convinced that participatory science can make a decisive contribution to research.
- 1. https://lafondation.3ds.com/fr/
- 2. Mathieu Lihoreau is an ethologist at the Research Centre on Animal Cognition (CNRS/Université de Toulouse III - Paul-Sabatier).
Explore more
Author
Anne-Sophie Boutaud studies scientific journalism at the Université Paris-Diderot. She holds a degree in history and political science.